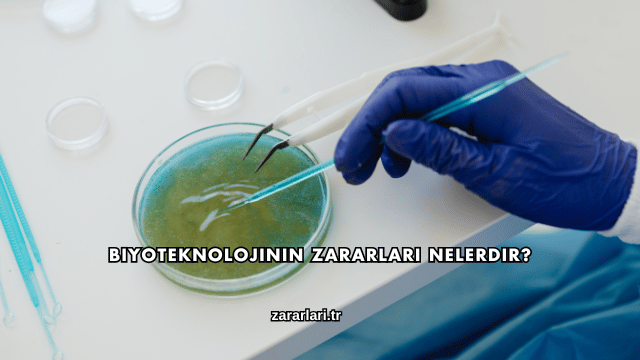

Biyoteknoloji, canlı organizmaların genetik yapısını değiştirerek tarımdan tıbba kadar birçok alanda yenilikler sunan bir bilim dalıdır. Ancak bu teknolojinin yanlış ya da bilinçsiz kullanımı çevresel, etik ve sağlık açısından bazı riskleri de beraberinde getirir. Bu yazıda biyoteknolojinin zararları nelerdir sorusuna kapsamlı bir şekilde yanıt verilecektir.
Biyoteknolojinin Çevresel Etkileri Nelerdir?
Biyoteknolojinin en çok tartışılan yönlerinden biri çevre üzerindeki etkisidir. Genetiği değiştirilmiş organizmalar (GDO’lar), doğal ekosistem dengesini bozabilir ve biyoçeşitliliği tehdit edebilir. Tarımda kullanılan GDO’lu bitkiler, böcek ilaçlarına dirençli hale gelirken çevrede yeni zararlı türlerin ortaya çıkmasına da neden olabilir.
Toprak ve Su Kaynakları Üzerinde Etkisi
GDO’lu ürünlerin yetiştirilmesinde kullanılan kimyasallar, toprak yapısında bozulmalara yol açabilir. Bu kimyasalların sulara karışması, hem içme suyu kalitesini düşürür hem de su ekosistemindeki canlıları olumsuz etkiler.
GDO’lar Toprak Verimliliğini Azaltır mı?
Evet, uzun vadede GDO’lu ürünlerin sürekli ekimi toprakta mikroorganizma dengesini bozar. Bu durum toprağın doğal besin döngüsünü zayıflatır ve verimliliği azaltabilir.

Doğal Türlerin Yok Olma Riski
Biyoteknolojik tarım uygulamaları, doğal türlerin genetik yapısının karışmasına neden olabilir. Bu da doğada saf türlerin azalmasına ve genetik çeşitliliğin azalmasına yol açar.
Biyoçeşitlilik Kaybı Nasıl Önlenebilir?
Bu durumun önüne geçmek için biyoteknolojik ürünlerin kontrollü bölgelerde yetiştirilmesi ve ekolojik dengeye zarar vermeyecek denetimlerin yapılması gerekir.
İnsan Sağlığına Etkileri Nelerdir?
Biyoteknoloji, sağlık alanında önemli yenilikler sunsa da bazı uygulamaları insan sağlığı açısından risk taşır. Özellikle genetiği değiştirilmiş gıdaların uzun vadeli tüketimi, bağışıklık sistemi ve hormonal denge üzerinde olumsuz etkilere yol açabilir.
Genetiği Değiştirilmiş Gıdaların Sağlığa Etkisi
GDO’lu besinlerin bazı bireylerde alerjik reaksiyonlara neden olduğu bilinmektedir. Ayrıca bu gıdaların uzun süreli tüketimi, vücut hücrelerinde beklenmedik genetik değişimlere yol açma riski taşır.
GDO’lar Kansere Neden Olur mu?
Bilimsel olarak doğrudan bir kanıt bulunmasa da bazı araştırmalar GDO’lu gıdaların hücresel bozulmalara neden olabileceğini ve bu durumun kanser riskini artırabileceğini göstermektedir.
Antibiyotik Direnci Oluşur mu?
Evet, biyoteknolojik üretimlerde kullanılan bazı gen aktarım teknikleri, insanlarda antibiyotik direncine yol açabilir. Bu durum, hastalıkların tedavisini zorlaştırarak sağlık sistemine büyük yük getirebilir.
Antibiyotik Direnci Nasıl Azaltılır?
Bu riski azaltmak için GDO üretiminde kullanılan genetik tekniklerin sınırlandırılması ve ürünlerin güvenlik testlerinden geçmesi gereklidir.
Etik ve Sosyal Sorunlar Nelerdir?
Biyoteknolojinin bir diğer önemli tartışma konusu etik sınırlardır. Genetik müdahaleler, doğanın dengesini ve insan yaşamının doğal akışını değiştirme potansiyeline sahiptir.
Genetik Müdahalenin Etik Boyutu
İnsan embriyolarına yapılan genetik müdahaleler, “tasarlanmış bebek” kavramını gündeme getirmiştir. Bu durum hem dini hem de etik açıdan büyük bir tartışma konusudur.
Genetik Müdahale Nerede Sınırlandırılmalı?
Etik kurallar, genetik müdahalenin yalnızca hastalık önleme amacıyla yapılmasını, insan özelliklerini değiştirme amacı taşımamasını öngörmektedir.
Sosyoekonomik Eşitsizlik Yaratır mı?
Evet, biyoteknolojiye erişim ekonomik güce bağlı olduğunda toplumlar arasında büyük bir eşitsizlik ortaya çıkabilir. Bu durum, sağlık hizmetleri ve tarım ürünlerine erişim açısından adaletsizlik yaratır.
Biyoteknolojiye Erişim Nasıl Dengelenebilir?
Kamu politikaları ve uluslararası iş birlikleriyle biyoteknolojiye erişimin tüm kesimler için eşit hale getirilmesi mümkündür.

Biyoteknolojinin Geleceğinde Hangi Tehlikeler Var?
Biyoteknoloji hızla ilerleyen bir alandır; ancak kontrolsüz gelişim ciddi sonuçlar doğurabilir. Yapay DNA ve klonlama çalışmaları etik sınırların ötesine geçtiğinde geri dönüşü olmayan sonuçlar yaratabilir.
Klonlama İnsan Genetiğini Tehdit Eder mi?
Klonlama, genetik çeşitliliği azaltarak doğanın evrimsel sürecine müdahale edebilir. Bu durum hem biyolojik hem de etik açıdan tehlike oluşturur.
Yapay Genetik Müdahaleler Nasıl Kontrol Edilmeli?
Bilimsel çalışmaların uluslararası etik kurullarca denetlenmesi ve belirli sınırların yasal olarak çizilmesi gereklidir.
Sıkça Sorulan Sorular
Aşağıda “Biyoteknolojinin Zararları Nelerdir?” ile ilgili sıkça sorulan sorular ve yanıtları yer almaktadır:
Biyoteknoloji İnsan Sağlığına Zarar Verir mi?
Kontrolsüz kullanıldığında genetik değişiklikler, alerjiler ve bağışıklık sorunları gibi riskler oluşturabilir. Ancak bilimsel denetimlerle bu zararlar büyük ölçüde azaltılabilir.
GDO’lu Ürünler Tüketmek Güvenli mi?
Bazı GDO’lu ürünler güvenlik testlerinden geçse de uzun vadeli etkileri tam olarak bilinmemektedir. Bu nedenle dikkatli ve sınırlı tüketim önerilir.
Biyoteknoloji Doğayı Nasıl Etkiler?
Doğal türlerin genetik yapısını değiştirebilir, ekosistem dengesini bozabilir ve biyolojik çeşitliliğin azalmasına neden olabilir.
Biyoteknolojinin Etik Sınırları Var mı?
Evet, birçok ülkede genetik müdahalelerin sadece tıbbi amaçlarla sınırlı kalması için yasal düzenlemeler yapılmıştır.
Biyoteknoloji Tarımı Nasıl Etkiler?
Kısa vadede verimliliği artırsa da uzun vadede toprak yapısını bozabilir ve doğal zararlılara karşı dayanıklılığı azaltabilir.
Gelecekte Biyoteknoloji Tehlikeli Hale Gelebilir mi?
Evet, etik sınırlar aşılır ve kontrolsüz genetik deneyler yapılırsa biyoteknoloji insan ve doğa için ciddi riskler oluşturabilir.